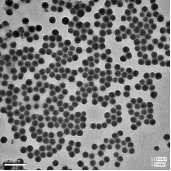
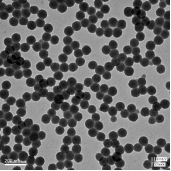
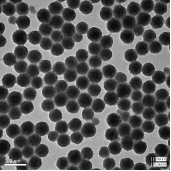
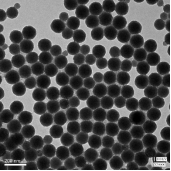

產品信息
硅溶膠
堿性硅溶膠
改性硅溶膠
酸性及中性硅溶膠
無機涂料專用硅溶膠
金屬硅
工業硅粉
微硅粉
性能指標
性能指標
型號 | SiO2 | Na2O | pH | 密度 | 黏度 (mPa·s) | 平均粒徑 (nm) | 外觀 |
JN-40-M25 | 38-41 | ≤0.4 | 9-11 | 1.28-1.30 | ≤30 | 25±5 | 微藍半透明 |
JN-40-M30 | 38-41 | ≤0.4 | 9-11 | 1.28-1.30 | ≤20 | 30±5 | 微藍半透明 |
JN-40-M40 | 38-41 | ≤0.4 | 9-11 | 1.28-1.30 | ≤15 | 40±5 | 微乳白 |
JN-40-M50 | 38-41 | ≤0.4 | 9-11 | 1.28-1.30 | ≤10 | 50±5 | 微乳白 |
JN-40-M80 | 38-41 | ≤0.4 | 9-11 | 1.28-1.30 | ≤5 | 80±10 | 乳白色 |
JN-40-M100 | 38-41 | ≤0.4 | 9-11 | 1.28-1.30 | ≤5 | 100±10 | 乳白色 |
JN-40-M120 | 38-41 | ≤0.4 | 9-11 | 1.28-1.30 | ≤5 | 110±10 | 乳白色 |

1.產品粒徑均勻為單分散體系,產品純度高、雜質離子含量低;
2.主要應用于CMP拋光,還可應用于涂料、涂層(粒徑均勻,可提高涂膜的均一性和光澤度)、紡織整理助劑等。
3.除所列型號的指標外,如有具體要求,可聯系業務人員進行定制。
包裝與存儲
1、采用25kg、250kg、1000kg聚乙烯塑料桶包裝。
2、在儲運過程中嚴禁冰凍和曝曬,搬運和堆碼時應輕拿輕放,防止撞擊。
3、儲存溫度5~40℃,避光保存,嚴禁日光直射,嚴禁低于0℃。